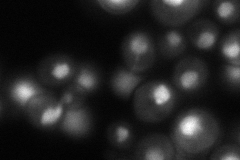
YGL048C
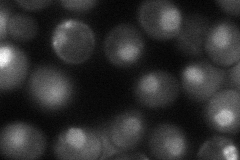
YGL048C
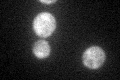
YGL048C

View description
One of six ATPases of the 19S regulatory particle of the 26S proteasome involved in the degradation of ubiquitinated substrates; bound by ubiquitin-protein ligases Ubr1p and Ufd4p; localized mainly to the nucleus throughout the cell cycle
Localization:
Intensity:
Fold change:
Significance:
-
C’ GFP library in SD

nucleus151.16 -
N' NOP1pr-GFP in SD

cytosol,nucleus160.704 -
N' TEF2pr-mCherry in SD

nucleus207.658 -
N' NATIVEpr-GFP in SD
nucleus107.342 -
N' TEF2pr-VC and Cyto-VN in SD
nucleus60.6207 -
C’ GFP library in SD+DTT

nucleus110.530.73No -
C’ GFP library in SD+H2O2

nucleus89.030.58Yes -
C’ GFP library in Starvation Media
nucleus61.450.4Yes -
C’ GFP library on the background of Pup2-DaMP

nucleus -
C’ GFP library on the background of CCT mutant

nucleusN/AN/ANo
